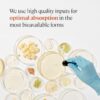
Frasco cerrado multivitamínico ANYA postnatal para mujeres

Marca: ANYA
Tamaño: 30 cápsulas (paquete de 1)
UPC: 196852301157
EAN: 0196852301157
- LACTANCIA: Durante la lactancia se requieren nutrientes elevados como B12, D, yodo y zinc que pasan por la leche materna y pueden agotar a la madre. Multivitamínico postnatal ANYA repone estas reservas para bebé y mamá.
- MANTENIMIENTO DE ENERGÍA: Vitaminas B esenciales para metabolismo energético, ayudan a convertir grasas y proteínas en energía. Contiene formas altamente biodisponibles para mejor absorción.
- ESTADO DE ÁNIMO POSTPARTO: Con vitamina D sostenible que refuerza el sistema inmune. Suplementar es necesario, sobre todo en dietas basadas en plantas.
- PÉRDIDA DE CABELLO Y PIEL SECA: El descenso de estrógeno puede causar caída de cabello y piel seca en el 50% de madres. Vitaminas A, C, E, zinc y biotina apoyan crecimiento capilar y producción de colágeno.
- PRUEBAS DE SEGURIDAD Y LIBRE DE ALÉRGENOS: Probado rigurosamente en cada etapa, libre de plomo, metales pesados, gluten y OMG. Libre de leche, huevos, cacahuetes, nueces, soya, trigo, pescado, mariscos y sésamo.

Valoraciones
No hay valoraciones aún.